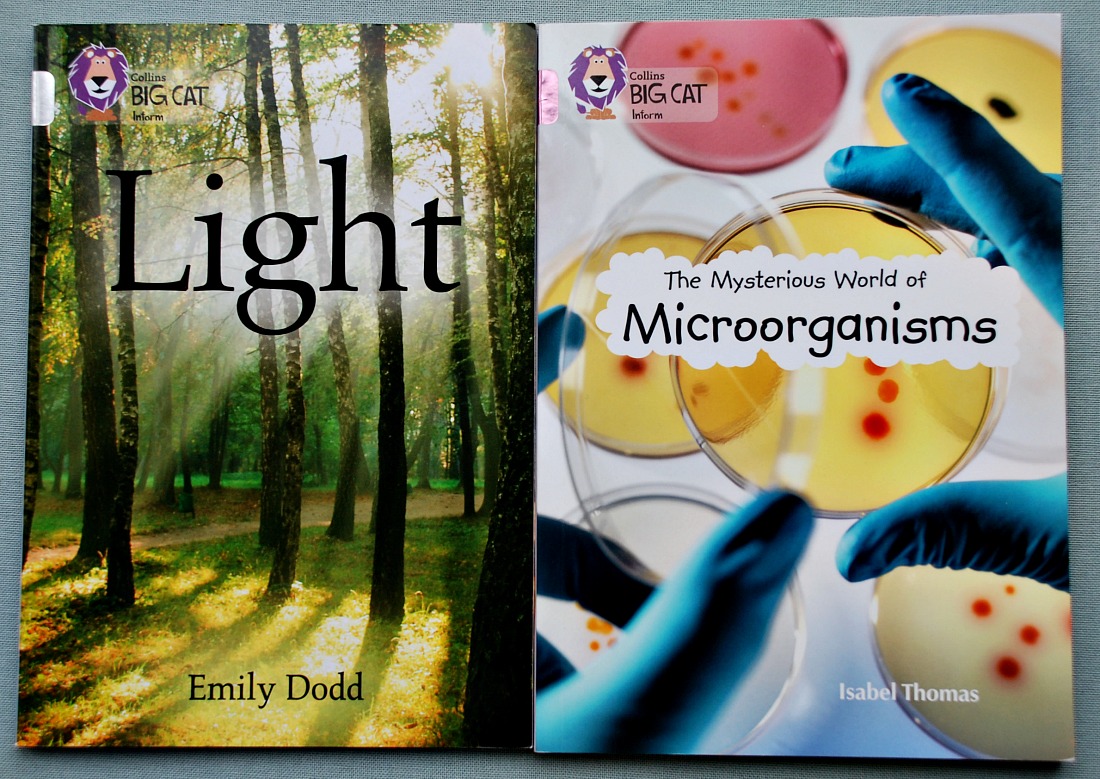
Science Books. Collins BIG CAT inform Books on Light and The Mysterious World of Microorganisms

Sticking with my starting year 7 resource idea posts this is what I have gathered for Science. Both my kids tend to heavily favour biology so we have actually already covered a lot of biology – especially animal biology but I was a bit concerned that we were not covering enough physics and chemistry (chemistry was a big area of concern for me) so this year I really wanted a more structured science book that I could use as a way of making sure we are getting to everything. I spoke to someone at Collins and they actually sent me their Key Stage 3 Science Student Book 1 as an option for Year 7 Science. Which looks like it is going to tick all the boxes. It breaks down the science into the three major sections and works through the topics in a logical manner. We have not yet started using the book but I have been reading through some of it and I like the set-up.
Each chapter starts with a quick introduction of what the topic is. Then they tend to discuss a new concept on a double page and the include questions on what they are talking about, lots of labelled diagrams (we really like this) and key words are written in bold and if the kids need to they can look these words up in the glossary at the back of the book. The paragraphs are good explanations, informative without being too wordy.
At the end of each chapter they also include a double page called “check your understanding” which is a summary of the key ideas that are covered in the chapter (this will be good to read through with the kids and see if they can explain the concepts) and there are also some additional questions at the end of the chapter.
Very briefly (I will write a detailed review once we have started using the book and I can give feedback about how my daughter is finding it) the student book covers
- Cells – structure, animal cells, plant cells, reproduction in plants and humans
- Eating, Drinking and Breathing – a healthy diet, the digestive system and the breathing system
- Mixing, Dissolving and Separating – including chromatography
- Elements, Compounds and Reactions – atoms, periodic table, metals and non-metals, combining elements.
- Forces and their Effects – types of forces, Hooke’s Law, friction, air and water resistance, calculations.
- Energy Transfers and Sound – how energy works and gets transferred, fuels, sound waves, speed of sound, reflection and absorption of sound.
To go with the student book I also purchased the Collins Year 7 workbook. I bought the workbook because I wanted exercises to go with the student book (the student book does contain questions after each topic but I wanted extra questions that my daughter could work through on her own, something to reinforce what we had learnt about in the student book). After looking at the two together I do think they are going to work well as a set. Just to mention the workbook is just black and white worksheets but I like it because it is logically set out and I only paid £4 for my workbook which I think is good value for money.
For extra examples I have actually already downloaded a LOT of the Twinkl Secondary Science section. We like their worksheets, especially the labelling pages.
We have not yet used any of the Twinkl Secondary Science pages but my daughter has been using their Secondary History and Secondary Maths over the past 4 months and those have been very useful so I am hoping the Science will be the same.
I have also joined the Teachit Science website (I set up a Free account which means I can download their PDF docs) and I have actually already used a few of their biology pages with the kids. I am finding all the Teachit sites very useful sites for educational resources.
My daughter is a visual learner and we tend do have a number of cork boards around the house (currently 7 boards) with different pages/ posters stuck up. It is a really simple concept but using posters really helps her so with my concern over chemistry I asked Schofield & Sims if we could get their Periodic Table Poster. I must admit I was very impressed when it arrived. I like how their have included little of notes about the elements and structure of the atom on the poster together with the actual periodic table.
I also decided that I am going to try and get more bite-sized science books for the kids (this is how I do History with my son and it has been working really well) so I am trying to adapt the same concept as a way of encouraging more Science with this sister. I am still looking around for books but so far I have these two lined up – Light and Microorganisms. I am planning on buying more during the upcoming year.
And finally our games. We found the Predators and Producers game worked really well as a biology activity and we recently started playing the Space Race game (physics game) so even though they are supposed to be Key Stage 2 games I am going to keep using them with my daughter as a fun way of reinforcing basic concepts. (Plus I have found the games work really well when you are educating different aged kids).
That is my starting point for Science. As we start working through our student book and covering topics I will add more activities and more books but I really wanted a framework for Science this year and I think the Collins book give us that we.
For those of you interested here are the Amazon links for the resources I mentioned (The poster and board games are not on Amazon but I have included links back to the companies that produce the products in the main text above).
Key Stage 3 Science – Student Book 1
KS3 Science Year 7 Workbook (Collins KS3 Revision)
Light: Band 17/Diamond (Collins Big Cat)
The Mysterious World of Microorganisms: Band 18/Pearl (Collins Big Cat)
Also if any of you missed my other Starting Year 7 posts here are the links for the English Literature one and the History one. I am hoping to have my Geography one finished this week and then a Maths one next week.
Admin Bit – the products used are a mix of items that I have been given (after I requested the specific items) and that I have bought. Collins sent us the Student Book and both BIG CAT inform books. Schofield & Sims gave me the poster and Oaka Books gave us both games.
I do include Affiliate links. If you follow an affiliate link and go on to purchase that product, I will be paid a very small commission, however your cost will remain the same. I only include affiliate links for products that we use.

Pingback: Most Used Year 7 Resources | ofamily learning together